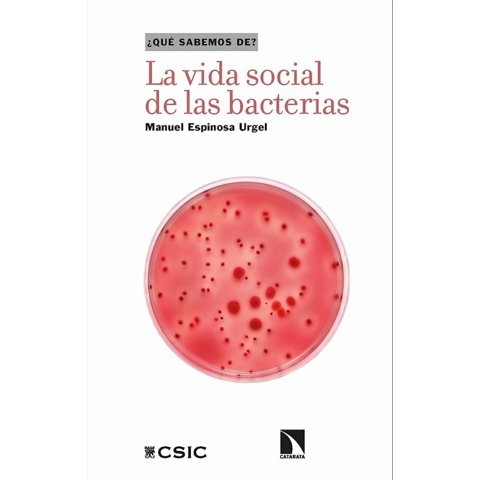

Océano
Océano - Libro La Vida Social De Las Bacterias Un Viaje Al Mundo D | Lider Electrohogar
Anterior:$ 16.732
Precio: $ 16.360
2%
Visitar Lider Electrohogar
Prueba buscando otros productos en:
Historial de precios
Fecha
02 Abr
Precio
$ 16.360
Océano - Libro La Vida Social De Las Bacterias Un Viaje Al Mundo D | Lider Electrohogar
$ 16.360
Visitar Lider Electrohogar
Características técnicas
Marca
Océano
Marca
Océano
Prueba buscando otros productos en:
Productos relacionados
Océano
Océano - Libro Un Best Seller Para Toda La Vida - Ryan Holiday
$ 22.490
$ 14.790
34%de descuento.
Océano
Océano - Libro Las Preguntas De La Embarazada - Jessica Hagy
$ 20.749
$ 20.288
2%de descuento.
Océano
Océano - Libro Vida - Jennifer N.R. Smith
$ 26.702
$ 26.109
2%de descuento.
Océano
Océano - Libro Sana Tus Raices Ancestrales Un Viaje Espiritual Hac
$ 25.474
$ 24.908
2%de descuento.
Océano
Océano - Libro El Mensaje De Dios Al Mundo - Neale Donald Walsch
$ 20.749
$ 20.288
2%de descuento.
Océano
Océano - Libro Las Siete Frecuencias De La Comunicación - Clotilde Leguil
$ 16.069
$ 15.712
2%de descuento.
Fce Chile
Fce Chile - Libro La Vida Social De La Energia 964
$ 16.254
$ 15.893
2%de descuento.
Océano
Océano - Libro La Reina De Las Nieves: Un Cuento De Navidad - Hans Christian Andersen; Sara Pilloni ( Iiustradora)
$ 15.619
$ 18.071
15%de aumento.
Océano
Océano - Un Segundo Amor. La Nacion De Las Bestias - Mariana Palova
$ 22.790
$ 14.890
34%de descuento.
Océano
Océano - Libro Vive Tu Mejor Vida En La 5D - José Manuel Valenzuela Arce
$ 18.859
$ 18.440
2%de descuento.
Océano
Océano - Libro Por Encima De La Ciudad, Por Debajo De Las Estrellas
$ 29.349
$ 28.697
2%de descuento.
Océano
Océano - Libro Las Singladuras Pendientes Entre America
$ 23.584
$ 23.060
2%de descuento.





